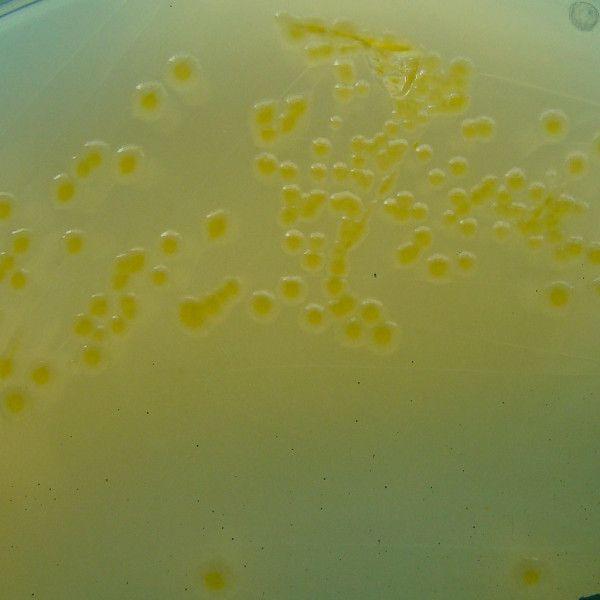

Οι περισσότεροι άνθρωποι καταλαβαίνουν από πρώτο χέρι πόσο σημαντικό είναι ένα υγιές μικροβίωμα όταν πρέπει να πάρουν αντιβιοτικό ευρέως φάσματος. Δυστυχώς, το φάρμακο δεν καταστρέφει μόνο τα παθογόνα μικρόβια, αλλά και τα «καλά» μικρόβια στο έντερο που σε διαφορετική περίπτωση από τη θέση που καταλαμβάνουν αποτρέπουν τους παθογόνους παράγοντες. Αυτός ο προστατευτικός μηχανισμός ονομάζεται αντίσταση αποικισμού. Ποια είδη μικροβίων είναι «καλά» ή «κοινά» κατά την ορολογία και πώς προστατεύουν από τον αποικισμό, δηλαδή πώς αποτρέπουν την εγκατάσταση παθογόνων;
Ο καθηγητής Τιλ Στρόβιγκ από το Γερμανικό Κέντρο Έρευνας Λοιμώξεων HZI και η καθηγήτρια Μπέρμπελ Στέχερ από το ίδιο κέντρο στο Μόναχο, αποφάσισαν να ρίξουν μια πιο προσεκτική ματιά.
Ο αντίπαλος της κλεμπσιέλας
Η Klebsiella pneumoniae είναι ένα από τα πιο τρομακτικά νοσοκομειακά μικρόβια, καθώς μπορεί να προκαλέσει σοβαρή πνευμονία, λοιμώξεις του ουροποιητικού συστήματος ή ακόμη και σήψη σε εξασθενημένους ασθενείς. Γίνεται δε, ολοένα και πιο ανθεκτικό στα κοινά αντιβιοτικά και μπορεί να διευκολύνει πρόσθετες λοιμώξεις. Σε συνεργασία με επιστήμονες στο Μαγδεμβούργο και το Ανόβερο, το τμήμα HZI με επικεφαλής τον Τιλ Στρόβιγκ, μπόρεσε να απομονώσει στελέχη ενός βακτηρίου από το έντερο που είναι εξαιρετικά αποτελεσματικά έναντι της K. pneumoniae. Πρόκειται για την Klebsiella oxytoca,η οποία χρησιμοποιεί τα ίδια σάκχαρα με το παθογόνο, αλλά το κάνει καλύτερα και δεν αφήνει αρκετά σάκχαρα για να επιβιώσει το παθογόνο. «Συγκεκριμένα η Κ. oxytoca μπορεί να εκδιώξει τα πολυανθεκτικά βακτήρια της K. pneumoniae επειδή τα εμποδίζει να λάβουν τη θέση όπου τα νοσοκομειακά αυτά βακτήρια μπορούν να δράσουν», εξηγεί ο Στρόβιγκ. Οι επιστήμονες μπόρεσαν επίσης να δείξουν σε ποντίκια ότι αυτά τα βακτήρια βοηθούν τη βακτηριακή σύνθεση στο έντερο να αναγεννηθεί γρηγορότερα μετά τη θεραπεία με αντιβιοτικά και να διασφαλίσει ότι αποκαθίσταται η προστασία από λοιμώξεις.

«Αρχικά θέλαμε να μάθουμε πόσο επιρρεπείς είναι οι υγιείς ενήλικες και παιδιά στον αποικισμό από πολυανθεκτικά βακτήρια K. pneumoniae», λέει η επικεφαλής συγγραφέας Λίζα Όσμπελτ για να εξηγήσει την προσέγγιση της μελέτης. Για τη μελέτη αυτή, οι επιστήμονες πήραν δείγματα κοπράνων από 100 υγιή άτομα και τα επώασαν με το μικρόβιο όλη τη νύχτα. Την επόμενη μέρα, μετρήθηκε η ανάπτυξη των βακτηρίων. Διαπιστώθηκε μεγάλη διαφοροποίηση στον αποικισμό ανάλογα με τη μικροβιακή κοινότητα στο έντερο του κάθε ατόμου. Στη συνέχεια, η ομάδα εξέτασε τα δείγματα στα οποία το μικρόβιο είχε αναπτυχθεί ελάχιστα. Σε πολλά από αυτά εντοπίστηκε το K. oxytoca. Οι ερευνητές στη συνέχεια δοκίμασαν τη συμπεριφορά των δύο βακτηρίων σε διαφορετικά μοντέλα ποντικών και διαπίστωσαν ότι η προσθήκη του K. oxytoca μπορεί να μειώσει σημαντικά την ευαισθησία στο νοσοκομειακό μικρόβιο του νοσοκομείου. Όταν ποντίκια χωρίς μικρόβια αποικίστηκαν με διαφορετικές ομάδες βακτηρίων (12 είδη συνολικά), τρία επιπλέον στελέχη συνεργάστηκαν με το K. oxytoca και έδωσαν προστατευτικό αποτέλεσμα.
Προστασία από σαλμονέλα
Ένα από τα πιο γνωστά βακτήρια στο ανθρώπινο έντερο είναι το Escherichia coli, ή εν συντομία E. coli. Συχνά αναφέρεται στους τίτλους ως «κακό» βακτήριο επειδή θεωρείται δείκτης μόλυνσης του πόσιμου νερού από τα κόπρανα και ορισμένες παραλλαγές του μπορεί να προκαλέσουν λοιμώξεις. Αλλά το βακτήριο έχει πολλά διαφορετικά στελέχη και εκτός από τις παθογόνες παραλλαγές, υπάρχουν και κοινοί εκπρόσωποι. Ωστόσο, μέχρι στιγμής λίγα γνωρίζουμε για το ρόλο αυτών των παραλλαγών στην ανθρώπινη υγεία. Η Μπάρμπελ Στέχερ και η ομάδα της στο Ινστιτούτο Max von Pettenkofer στο LMU ανακάλυψαν πριν από λίγο καιρό ότι το κοινό E. coli προστατεύει από τη μόλυνση από σαλμονέλα. Και πάλι, οφείλεται στην κατανάλωση ζάχαρης που περιορίζει την ανάπτυξη της σαλμονέλας καθώς της στερείται η τροφή.
Διαβάστε επίσης: Σαλμονέλα : Όλα όσα πρέπει να ξέρετε για τη βακτηριακή μόλυνση
Στην τρέχουσα μελέτη, οι ερευνητές μπόρεσαν να αποδείξουν ότι αυτή η προστατευτική επίδραση του E. coli εξαρτάται επίσης από το μικροβιακό περιβάλλον στο έντερο. Αυτό σημαίνει ότι εξαρτάται από τους μικροοργανισμούς που υπάρχουν ήδη, με άλλα λόγια, εάν το E. coli έχει «καλή παρέα».
Όπως εξηγεί η Στέχερ, «εάν υπάρχουν Lachnospiraceae στο μοντέλο μας που μπορούν επίσης να μεταβολίσουν απλά σάκχαρα, το E. coli μπορεί να παρέχει προστασία – αλλιώς, δεν μπορεί.. Συνολικά, τώρα καταλαβαίνουμε καλύτερα γιατί τα προβιοτικά μπορεί επίσης να βοηθήσουν μερικούς, αλλά όχι όλους. Ο λόγος είναι το μικροβιακό περιβάλλον, το οποίο διαφέρει πολύ από άτομο σε άτομο».

Προστατευτικό κοκτέιλ μικροβίων
Η μελέτη εκατοντάδων βακτηρίων και άλλων μικροοργανισμών του μικροβιώματος είναι απίστευτα πολύπλοκο εγχείρημα – ακόμη και στα ποντίκια. Με το μοντέλο ποντικιού που αναπτύχθηκε στο Μόναχο, οι επιστήμονες μπορούν να διερευνήσουν τον αποικισμό και την επίδραση των παθογόνων μικροοργανισμών με συγκεκριμένο στόχο. Ένα συνθετικό κοκτέιλ 12 βακτηριακών στελεχών αποικίζει ποντίκια χωρίς μικρόβια, σταθερά για αρκετές γενιές και σχηματίζει ένα εντερικό μικροβίωμα αντιπροσωπευτικό των ποντικών. Και οι δύο μελέτες που περιελάμβαναν Klebsiella και E. coli αντίστοιχα, χρησιμοποιούν αυτό το μοντέλο για να εντοπίσουν τις αλληλεπιδράσεις στην εντερική χλωρίδα. Αλλά ακόμη και στα ποντίκια, είναι σαφές πόσο περίπλοκες είναι οι αλληλεπιδράσεις. Ωστόσο, οι μελέτες των ερευνητών μικροβίων δίνουν ελπίδα, επειδή δείχνουν για άλλη μια φορά ότι είμαστε στο σωστό δρόμο.



